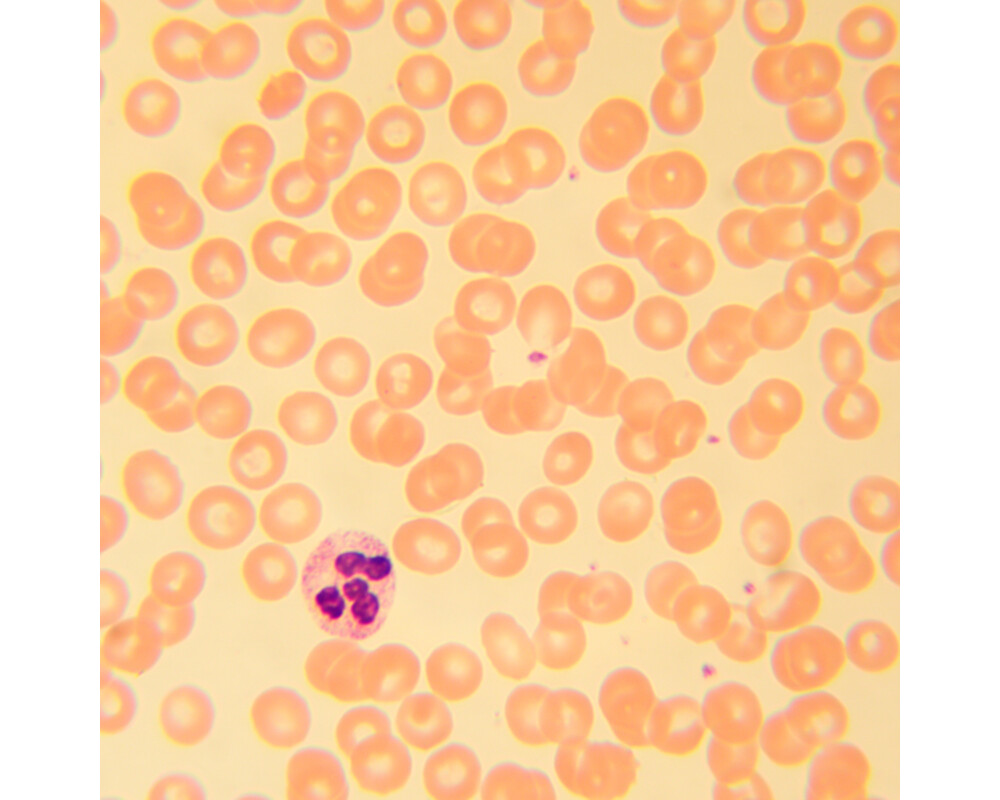

- Начало
- Оптични уреди и измервателни инструменти
- Микроскопи
- Magus
- Биологичен MAGUS Bio 230B (ID: 686450)
Микроскоп Биологичен MAGUS Bio 230B 82892
Плати по-лесно и сигурно с
ID: 686450
Характеристики
| Тип | биологичен, светлина/оптичен |
| Подходящо за | лабораторно/медицинско |
| Употреба | за професионалисти, опитни потребители |
| Монтаж и инсталиране | сложен |
| Technique | на светлото поле |
| Head | глава Gemel (Siedentopf, завъртане на 360°) |
| Head angle | 30 ° |
| Revolver | за 5 обектива |
| Увеличение, x | 40 — 1000 x |
| Окуляри | 10x/18 mm, разстояние от очите: 10 mm (*опция: 10х/20 mm със скала, 15x/11 mm, 16x/11 mm; 20x/11 mm) |
| Диаметър на окуляра | 23.2 мм. |
| Диоптрична корекция на окуляра | ±5 (на лявата тръба) |
| Фокусиране | коаксиален, грубо фокусиране (21 mm, 39,8 mm/кръг, със застопоряващ бутон и бутон за регулиране на затягането) и фино фокусиране (0,002 mm) |
| Diaphragm | диафрагма с регулируема апертура, полева диафрагма с регулируем ирис |
| Objectives | ахроматични с корекция до безкрайност: 4x/0,10; 10x/0,25; 40xs/0,65; 100xs/1,25 (масло); парфокално разстояние 45 mm (*опция: 20x/0,40; 60xs/0,80) |
| Филтри | да |
| Working distance | 18,89 (4x); 5,95 (10x); 0,775 (40xs); 0,36 (100xs); 2,61/8,80 (20x); 0,46 (60хs) mm |
| Разстояние между окулярите (IPD), mm | 48 — 75 мм. |
| Condenser |
кондензер Abbe
N.A. 1,25 с регулируем център регулируема височина диафрагма с регулируема апертура слот за плъзгач за метода на тъмното поле и плъзгач за фазовоконтрастно наблюдение монтировка тип „лястовича опашка“ |
| Light source type | халогенно |
| Light source | халогенна крушка 12 V/30 W, G4 |
| Light source placement | долно |
| Brightness control |
|
| Expansion | фазовоконтрастно устройство (кондензер и обективи), кондензер за метода на тъмното поле в имерсионно масло (сух или в масло), устройства за поляризация (поляризатор и анализатор) |
| Camera operating temperature | 5 — 35 °С |
| Stage | 180x150 мм. |
| Stage adjustment | 75/50 |
| Stage features | двуосова механична предметна маса, без рейка за позициониране |
| Размери на продукта | 43x27x63 cm см. |
| Захранване | 220±22 V, 50 Hz, променливотокова мрежа |
| Тегло | 10 kg кг. |
| Гаранция | 24 месеца |
| Код на продукта | 82892 |
Виж повече
Допълнителна информация
<p>Микроскопът Magus Bio 230B е предназначен за лабораторни и научни изследвания с цел наблюдение на биологични образци, като тънки разрези или натривки. За анализ на образците се използва техниката на микроскопия с преминаваща светлина (метод на светлото поле). Ако е необходимо, микроскопът може да бъде оборудван с допълнителни принадлежности за метода на тъмното поле, с поляризирана светлина и фазов контраст. Микроскопът може да се използва в области като фармацевтичната промишленост, медицината, биотехнологията, опазването на околната среда, криминалистиката и селското стопанство.</p>
<p><strong>Оптика</strong> </p>
<p>Микроскопът е с бинокулярна глава. Наблюдателните тръби могат да се завъртат на 360°, което позволява на потребителя да регулира позицията съобразно неговата височина. На лявата тръба има пръстен за регулиране на диоптъра. Револверната глава с обективи има 5 слота и е ориентирана навътре – потребителят може да вижда обективите, поставени в оптичния път, а пространството над предметната маса е свободно. В комплекта са включени четири ахроматични обектива, а петият слот може да се използва за монтиране на допълнителен обектив.</p>
<p>Оптичните елементи са коригирани до безкрайност. Базовият диапазон на увеличение на микроскопа е от 40 до 1000x. Чрез допълнителни обективи той може да бъде разширен до 1500, 1600, и 2000x. Ако е необходимо, в тръбата на окуляра може да се монтира цифров фотоапарат (не е включен).</p>
<p><strong>Осветление</strong></p>
<p>Светлинният източник е халогенна крушка, която се намира в основата на микроскопа. Топлата светлина намалява напрежението на очите и е идеална за продължителна работа с микроскопа. Халогенната лампа с мощност 30 W осигурява възможност за получаване на ярки изображения с голям контраст, с всеки тип обектив и всеки микроскопски метод (включително този на тъмното поле и фазов контраст).</p>
<p>Кондензерът на Abbe може да се центрира и неговата височина може да се настройва. Плъзгачът за метода на тъмното поле или за фазовоконтрастно наблюдение може да се монтира в специален слот, което Ви дава възможност за лесно превключване между микроскопските методи. Полевата диафрагма прави възможно монтирането на осветление на Кьолер.</p>
<p><strong>Предметна маса и механизъм за фокусиране</strong></p>
<p>Предметната маса няма рейка за позициониране, което улеснява работата с микроскопа. Механично приспособление, което може да се маха при необходимост, осигурява плавно преместване на образеца по предметната маса.</p>
<p>Бутоните за грубо и фино фокусиране са коаксиални (на една и съща ос) и се намират от двете страни в долната част на микроскопа. Такова разположение на бутоните за фокусиране Ви позволява да подпрете ръцете си свободно на масата и да седите удобно при продължителна работа. Регулирането на фокуса е плавно и не изисква допълнителни усилия. Грубото фокусиране има застопоряващ бутон и бутон за регулиране на затягането.</p>
<p><strong>Принадлежности</strong></p>
<p>Допълнително оборудване, като обективи, окуляри, устройства за фазовоконтрастно наблюдение, кондензери за метода на тъмното поле, поляризиращи устройства, цифрови фотоапарати или други принадлежности, ще разшири възможностите на микроскопа. Те са предназначени за Magus Bio 230B и се предлагат по заявка.</p>
<p><strong>Основни характеристики:</strong></p>
<ul>
<li>Ахроматична оптика, коригирана до безкрайност</li>
<li>Бинокулярна глава, наблюдателните тръби могат да се завъртат на 360°, регулиране на диоптъра на лявата тръба</li>
<li>Револверна глава за 5 обектива, предметна маса без рейка за позициониране</li>
<li>Бутон и за грубо и фино фокусиране, бутон за регулиране на затягането при грубо фокусиране, бутон за застопоряване при грубо фокусиране</li>
<li>Кондензер със слот за плъзгач за фазоконтрастно наблюдение или такова по метода на тъмното поле, полева диафрагма за осветление на Кьолер </li>
<li>Халогенна лампа 30 W (източник за пропускаща светлина), с регулируема яркост, с променливотоково захранване</li>
<li>Опция за монтиране на допълнителни принадлежности за разширяване на възможностите на микроскопа</li>
</ul>
<p><strong>Комплектът включва:</strong></p>
<ul>
<li>Основа с вход за захранване, светлинен източник за преминаваща светлина, механизъм за фокусиране, предметна маса, кондензер и револверна глава</li>
<li>Бинокулярна глава </li>
<li>Ахроматичен обектив с корекция до безкрайност: 4x/0,1</li>
<li>Ахроматичен обектив с корекция до безкрайност: 10x/0,25</li>
<li>Ахроматичен обектив с корекция до безкрайност: 40x/0,65 (пружинно натоварен)</li>
<li>Ахроматичен обектив с корекция до безкрайност: 100x/1,25 (пружинно натоварен) </li>
<li>Окуляри 10x/18 mm с голямо разстоянието от очите (2 бр.)</li>
<li>Чашки на окулярите (2 бр.)</li>
<li>Филтри (4 бр.)</li>
<li>Бутилка с имерсионно масло</li>
<li>Шестостенен ключ</li>
<li>Променливотоково захранване</li>
<li>Покривало против прах</li>
<li>Ръководство за потребителя и гаранционна карта</li>
</ul>
<p><strong>Предлагат се по заявка:</strong></p>
<ul>
<li>Окуляр 15x/11 mm (2 бр.)</li>
<li>Окуляр 16x/11 mm (2 бр.)</li>
<li>Окуляр 20x/11 mm (2 бр.)</li>
<li>Ахроматичен обектив с корекция до безкрайност: 20x/0,4</li>
<li>Фазовоконтрастно устройство</li>
<li>Плъзгач за фазовоконтрастно наблюдение</li>
<li>Кондензер за тъмно поле NA 0,9</li>
<li>Кондензер за метода на тъмното поле в имерсионно масло NA 1,36–1,25</li>
<li>Плъзгач за метода на тъмното поле</li>
<li>Устройство за поляризация</li>
<li>Цифрова камера</li>
<li>Калибрационен образец</li>
</ul>
Виж повече
Допълнителна информация
Виж повече
Информация за производителя
| Контакт | [email protected] |
| Адрес | ул. Акад. Стефан Младенов 46, София, 1700, България |
| Уебсайт | https://magusmicro.bg/ |
Виж повече
Ние от PIC.bg постоянно полагаме усилия информацията на тази страница да е точна. В редки случаи съдържанието може да е некоректно. Всички снимки са с информативна цел и е възможно да съдържат аксесоари, които не са включени в стандартния пакет. Някои от спецификациите или цените могат да бъдат променяни от производителя без предизвестие или да съдържат експлоатационни грешки. Всички промоции, посочени в сайта, се предлагат до изчерпаване на количествата.
Отзиви
0.0
0 отзива.
5
0
4
0
3
0
2
0
1
0
Оцени продукта
Добави отзив